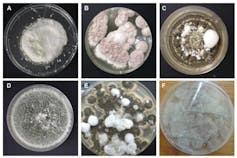
Six Petri dishes are pictured, labeled A through F, each containing a different kind of fungus

Gardeners the world over dread the appearance of aphids on their plants. There are around 4,000 species of these sap-sucking insects and about 250 are pests that can wreak havoc on crops in a garden or orchard.
One of them is the woolly apple aphid (Eriosoma lanigerum). As its name suggests, this aphid attacks apple trees and is recognisable by the white, waxy excretions that cover and protect the insects.
The aphid is native to the US and can be found throughout the world wherever apples are cultivated. It was first identified in South Africa in 1895 and has, over time, become a serious pest of apples.
The aphids infest apple trees through the plants’ root systems and above-ground growth. The colonies cause abnormally large swellings on apple roots, impeding the flow of nutrients and water throughout the plant. If the infestation is not controlled, a tree’s buds, shoots and fruit-bearing wood can be entirely destroyed. The mother insect on the roots produces live young called crawlers, which migrate from the roots to above-ground parts of the apple tree. Young trees and new cultivars of apples are especially vulnerable.
In 2023, South Africa produced 1.3 million tonnes of apples, with 544,759 tonnes exported. Apple cultivation covers over 25,000 hectares; the primary growing area of 15,000 hectares is located in the Western Cape province, particularly in the Ceres and Groenland regions. The estimated value of apple production in 2023 was R8,794 (about US$490) per tonne.
The most common method of controlling woolly apple aphid infestations in orchards has, for the past several decades, involved applying high doses of chemical insecticides. Many apple growers globally, including South African producers, have reported that the insects seem to have become resistant to these insecticides. This, along with concerns about the harmful effects of chemicals on the environment, has led scientists to look for new insect control methods.
Author provided (no reuse)
We are biologists at Stellenbosch University’s Department of Conservation Ecology and Entomology, conducting research on insect-killing fungi and nematodes to control pest insects. In a recent academic article we examined whether entomopathogenic fungi could help to keep South Africa’s apple trees safe from woolly apple aphid. These fungi are naturally found in all soils in low numbers, where they keep insect populations under control.
We wanted to know whether the fungi could be used for biocontrol, an approach that involves using living organisms to control pests. The results were clear: three of the six fungi species we tested were extremely fast and effective at infecting and destroying woolly apple aphids.
Soil samples
For our study, we obtained soil samples from different apple orchards in the Western Cape province and used susceptible insects (mealworms) to trap fungi from the soil.
The isolated fungi were grown on agar in Petri dishes and once the spores became visible we harvested them and dipped woolly apple aphid females into a specific concentration to assess their killing potential. (The females fertilise themselves and do not need males for this purpose.)
The fungal spores attached to the insects, sending a sort of tube into the aphids and making spores that appeared on the outside of their bodies. These spores can be mass produced and used in high concentrations to naturally kill the target pest.
Two of the fungi were exceptionally effective at infecting and killing the woolly apple aphid females within five days. That’s remarkably fast for fungi, which usually take between 7 and 14 days to kill and develop spores on the outside of insects’ dead bodies.
Author provided (no reuse)
We’re very excited by these results – particularly since, to our knowledge, our research group is the first ever to test entomopathogenic fungi for use in the control of woolly apple aphid.
A new control tool
There are many commercial products on the market that contain entomopathogenic fungi for the control of insects. Their application in high concentrations does not have a negative ecological effect since they already occur naturally in low numbers in targeted environments.
Now that we know what the local entomopathogenic fungi species we studied are capable of, we plan to test them under more natural conditions. This includes using them on apple trees that grow under cover (such as in glasshouses, shade houses and tunnels). Mass culture and formulation are especially important to ensure the fungi will work on a commercial scale.
Ultimately we hope to approach local commercial companies to mass-produce these specific fungal species. This will be a step towards helping apple growers control the woolly apple aphid, avoid insecticide resistance issues and reduce environmental pollution from chemicals.